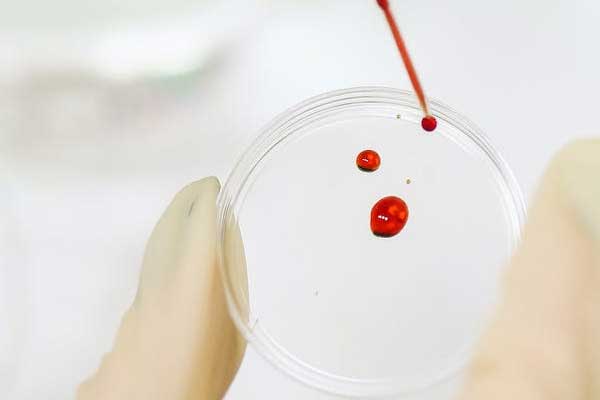

由于教师待遇的不断提高,稳定性较强,越来越多其他专业的学生想通过考研进入到教育行业。内江找教育学考研辅导班,比较不错的是中公教育,这是一家专注考研的连锁机构,拥有强大的师资阵容、深厚的自主研发实力,以学员为根本,提供专业的教学服务,受到学员的一致好评,感兴趣的朋友可以到就参观考察,试听体验。
一、教育学考研
有哪些专业?好考吗?难不难?
教育学考研专业包括:教育学原理,课程与教学论,教育史,比较教育学,学前教育学。涵盖面较广,需要背诵的内容多且杂,考生可以根据自己的学习状况和经济能力报辅导班或者自己进行复习。内江考研机构针对不同专业的考研学子,成立热门专业课项目部,匹配研发,定向定专业辅导,是不错的选择。
分数线
| 教育学 | A类 | B类 | ||||
| 总分 | 单科 满分=100分 |
单科 满分>100分 |
总分 | 单科 满分=100分 |
单科 满分>100分 |
|
| 2020年 | 331 | 46 | 138 | 321 | 43 | 129 |
| 2021年 | 337(↑4分) | 47(↑1分) | 141(↑3分) | 327(↑4分) | 44(↑1分) | 132(↑3分) |
二、内江教育学考研辅导班
1、机构介绍
中公考研是中公教育旗下项目,以学员为根本,凭借强大的师资团队和自主研发实力,打造专业的考研辅导课程,包括教育学、体育学、心理学、经济学、管理学、计算机、医学、新闻与传播、翻译硕士、艺术学等,提供精细化的教学服务,为不同专业的考生制定专属课程产品;弥补考生课堂知识的短板,逐步培养考生的竞争优势。

2、培训课程
| 课程班型 | 课程内容 | 配套服务 |
| 速学全科直播班 | 公共课:基础夯实课+精讲考点课+实战训练课;5年试题精讲+模考测试(3次)+冲刺点睛课 专业课:定向专业特训课(非统考定向专业+10课时1对1);非定向专业课(20课时/30课时1对1) 增值课:早安班+晚安班带背 复试课:复试网课(综面+口语) |
择校择专指导+5次备考规划+答疑服务;测试服务+批改小课堂(6次)+师资带背团;学情反馈+班级管理+1v1心理疏导 |
| 速学全科初试班 | 公共课:基础夯实课+暑期集训(云集训/面授45天);实战训练课+5年试题精讲+模考测试(5次);冲刺点睛课 专业课:定向专业特训课(非统考定向专业+10课时1对1);非定向专业课(20课时/30课时1对1) 增值课:早安班+晚安班带背 10课时1对1能量包 复试课:复试标准班(线上/面授)+复试网课 |
择校择专指导+5次备考规划+答疑服务;测试服务+批改小课堂(9次)+师资带背团;学情反馈+班级管理+1v1心理疏导 |
| 速学全科无忧班(1v20小班) | 公共课:基础夯实课+暑期集训(云集训/面授45天);实战训练课+5年试题精讲+模考测试(7次);冲刺点睛课(云集训/面授30天) 专业课:定向辅导直播课(非统考定向专业加10课时1对1);非定向专业课(20课时/30课时1对1) 增值课:早安班+晚安班带背 20课时1对1能量包 复试课:复试协议班(线上/面授)+复试网课 |
择校择专指导+5次备考规划+答疑服务;测试服务+批改小课堂(16次)+师资带背团;学情反馈+班级管理+1v1心理疏导 |
3、学费价格多少钱
内江中公考研课程费用根据班型、上课方式及专业内容而定,一般单科费用在1500-5000元左右,全科费用2-3万元不等,详细的费用情况可以咨询在线老师。

4、教学特色
(1)定制辅导方案:
我们通过对历年考研学生的跟踪研究形成大数据系统,深刻剖析深层原因,对于每一类的同学,我们都有针对性的备考方案。
(2)反转式课堂理念
可以随时随地,每一节课,每一个自习与中公讲师进步互动教学,互动答疑。可以随时提出问题,然后以问题为核心展开讨论。
(3)切片式教学稳步强化
通过数据整合,总结出多个重难点切片,并将这些重难点分为四个学习阶段:基础阶段,强化阶段,实战阶段,冲刺阶段。针对学员每一阶段的学习状况我们都有针对性地考点讲解。
三、教育学考研考试
1、考试科目
教育学研究生考试从2007年开始全国统考,教育学研究生考试科目为:思想政治理论、外国语、教育学专业基础综合三门科目,由教育部统一命题。
2、考试时间
2022年教育学考研考试初试时间为12月24日至25日。详细考试时间、考试科目及有关要求等由考点和招生单位予以公布。
